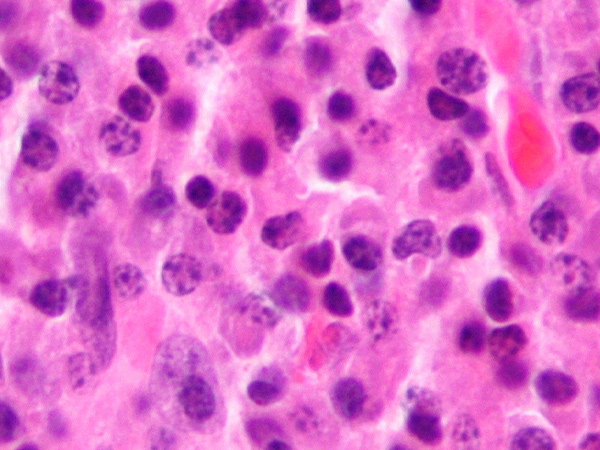

Preventing Bone Complications for Multiple Myeloma Patients
The FDA has expanded the use of a molecularly targeted therapeutic to include patients with multiple myeloma.
The U.S. Food and Drug Administration (FDA) recently approved expanding the use of the molecularly targeted therapeutic denosumab (Xgeva) to include the prevention of bone complications in patients with multiple myeloma.
Multiple myeloma is the second most commonly diagnosed hematologic (blood) cancer in United States, with more than 30,000 new cases diagnosed annually in recent years.
Multiple myeloma arises in immune cells called plasma cells. The cancer cells accumulate in bone marrow – the soft, sponge-like tissue in the center of certain bones – which can damage and weaken the bone. In fact, bone pain is one of the most common symptoms experienced by patients prior to diagnosis and bone complications, including fractures, are a hallmark of the disease.
Denosumab targets a protein called RANKL, which is important for the function and survival of a type of bone cell called an osteoclast. Signals to osteoclasts via RANKL cause them to break down bone, which reduces bone density and strength. Blocking RANKL with denosumab prevents this from happening, helping maintain bone density and strength.
Denosumab was first developed and FDA approved for the treatment of postmenopausal women with osteoporosis who are at high risk for bone fractures. When used in this way, denosumab is sold under the brand name Prolia.
Denosumab was later approved by the FDA under the brand name Xgeva for the prevention of bone complications, including fractures and spinal cord compression, in patients with bone metastases from solid tumors; the treatment of giant cell tumor of the bone; and the treatment of hypercalcemia of malignancy, which is a side effect of cancer experienced by up to 30 percent of individuals diagnosed with cancer.
Until now, the only drugs approved for preventing the bone complications experienced by patients with multiple myeloma were bisphosphonates – a group of drugs that help maintain bone density and strength by suppressing bone destruction by osteoclasts and promoting osteoclast death. However, new therapeutic options are needed because the use of bisphosphonates in preventing the bone complications of multiple myeloma is sometimes limited by the fact that these drugs can cause damage to the kidneys, which are organs of the body commonly already damaged due to the multiple myeloma itself.
The approval of denosumab for prevention of bone complications in patients with multiple myeloma was based on results from the randomized phase III 482 clinical trial, which were presented last year at the 16th International Myeloma Workshop. In the study, denosumab was found to be as good as the bisphosphonate zoledronic acid in delaying the time to the first bone complication. The median time to the first bone complication after starting treatment was 22.83 months for those receiving denosumab and 23.98 months for those receiving zoledronic acid.
The adverse events reported among those receiving denosumab and zoledronic acid were consistent with what is known already about the two treatments. Among those receiving denosumab, the frequency of adverse events related to kidney damage was lower and the frequency of osteonecrosis of the jaw was higher compared with those receiving zoledronic acid.
The FDA approval was rendered on January 4, 2018.